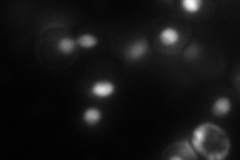
YBL093C
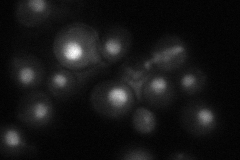
YBL093C
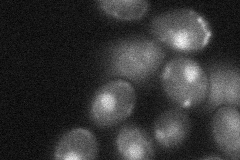
YBL093C
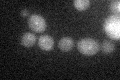
YBL093C

View description
Subunit of the RNA polymerase II mediator complex; associates with core polymerase subunits to form the RNA polymerase II holoenzyme
Localization:
Intensity:
Fold change:
Significance:
-
C’ GFP library in SD

below threshold18 -
N' NOP1pr-GFP in SD

nucleus75.9327 -
N' TEF2pr-mCherry in SD
nucleus62.5193 -
N' NATIVEpr-GFP in SD
nucleus49.4141 -
N' TEF2pr-VC and Cyto-VN in SD
nucleus28.3409 -
C’ GFP library in SD+DTT
cytosol16.260.9No -
C’ GFP library in SD+H2O2

cytosol13.110.72No -
C’ GFP library in Starvation Media

cytosol14.380.79No -
C’ GFP library on the background of Pup2-DaMP

below threshold -
C’ GFP library on the background of CCT mutant

below threshold18.2061.01134No
